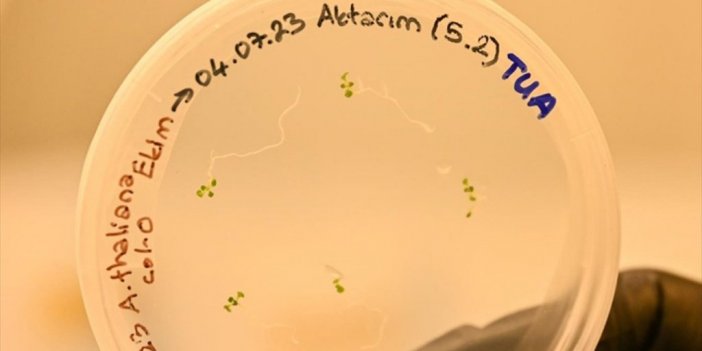
Türk Bilim İnsanları Uzayda Bitki Yetiştirecek

Çorum'da Silo Olduğu Değerlendirilen 3 Bin 300 Yıllık Yapı Bulundu
Çorum'un Ortaköy ilçesindeki Şapinuva Antik Kenti'ndeki arkeolojik kazıda, silo olabileceği değerlendirilen yaklaşık 3 bin 300 yıllık yapı bulundu.
Hititlerin önemli şehirlerinden Şapinuva'da 1990 yılında başlayan arkeolojik kazılar, Hitit Üniversitesi Fen Edebiyat Fakültesi Arkeoloji Bölümü'nden Doktor Öğretim Üyesi Önder İpek başkanlığında, Türk Tarih Kurumu Başkanlığı finansal desteğiyle sürüyor.
Farklı üniversitelerden akademisyenlerin yer aldığı kazı ekibi, binlerce yıllık geçmişe sahip alanda tarihin izini sürüyor.
Kazı Başkanı İpek, AA muhabirine, Hitit döneminde bölgede kurak iklime uygun tarım yapıldığını ve buna bağlı hububat depolarının oluşturulduğunu söyledi.
Hititlerin diğer önemli kentleri Hattuşa ve Alacahöyük'te de daha önce silolar bulunduğunu belirten İpek, "2022'den itibaren yürüttüğümüz çalışmada bu yapının bir silo olabileceğine dair kanaatlerimiz arttı. Teknik çalışmalar bu alanın gerçekten bir silo mu yoksa başka bir işlevinin olup olmadığını bize verecek." dedi.
Şapinuva'daki silo olduğu değerlendirilen yapının yaklaşık 150 ton saklama kapasitesine sahip olduğunu dile getiren İpek, bu tür siloların kralın halka karşı gücünü göstermesi, ayrıca kıtlık dönemleri için buğday saklanması açısından sona derece önemli yapılar olduğunu vurguladı.
Şapinuva'nın M.Ö. 14'üncü yüzyılda bir dönem başkent olarak kullanıldığını hatırlatan İpek, buradaki Ağılönü bölgesindeki iki siloya ek olarak yeni bir silo bulunmasının o dönem ne kadar önemli bir şehir olduğunu ortaya koyduğunu vurguladı.
Boğazköy ve Alacahöyük'teki silolarla benzerlik gösteriyor
Şapinuva'daki arkeolojik kazılara 15 yıldır katılan Hitit Üniversitesi Fen Edebiyat Fakültesi Arkeoloji Bölümü Araştırma Görevlisi Semih Gerçek ise silo olduğunu değerlendirdikleri yapının toprak oyularak oluşturulduğunu aktardı.
Önemli bir keşif yaptıklarına değinen Gerçek, "10 metreye 5,5 metre ölçülerinde, 3 metre derinliğindeki bir yapı. 55 metrekare alana ve 165 metreküplük boyuta sahip. Burayı kazarken iki çivi yazılı tablet ve yanmış kerpiç parçaları bulduk. Bunların bu yapıyla ilgisinin olmadığını, dolgu malzemesi olarak kullanıldığını gördük." diye konuştu.
Yapının zemininde çapraz şekilde dizilmiş taşların kesiştiği bir çukur bulunduğunu anlatan Gerçek, "Bu çukura doğru bir eğim var. Bunun suyla, nemle ilgili olduğunu düşünmekteyiz. Bunu Anadolu'daki diğer Hitit örnekleriyle değerlendirdiğimizde Alacahöyük ve Boğazkale'deki örneklerini göz önüne aldığımızda bir silo ile karşı karşıya olduğumuzu düşünmekteyiz. Bu sene çalışmalarını yeni tamamladık, tabana yeni ulaştık. Çeşitli karbon analizleri yapacağız, aynı zamanda taban toprağından ve özellikle orta kısmından aldığımız toprağın eleme çalışmalarını yapıyoruz. Herhangi bir tahıl parçası elimize geçerse, bu konudaki fikirlerimizi destekleyecek ve Ortaköy'de Ağılönü'nden sonra ikinci bir silo olarak karşımıza çıkacak." ifadelerini kullandı.
Silonun 150 ton tahılla doldurulduğu tahmin ediliyor
Şapinuva'daki yapının Boğazköy ve Alacahöyük'teki silolarla yapı açısından benzerlik gösterdiğine dikkati çeken Gerçek, şunları kaydetti:
"Boğazköy ve Alacahöyük'teki silolar ana toprak içerisine oyulmuş ya da tabanları taşla kaplı ama Ortaköy'deki silo olarak düşündüğümüz alanın tabanı taşla kaplı değil, tamamıyla ana toprak. Ana toprağın içine oyulması sadece siloda görünmüyor, biz bunu aynı zamanda kurban çukurlarında, işlik yapılarında, çöp çukurlarında da görüyoruz. Bu tamamıyla Ortaköy'e özel bir durum. Hesapladığımızda eğer çalıştığımız alan bir silo ise ki bütün göstergeler onu gösteriyor, bu alanın yaklaşık 150 ton buğday, arpa ya da mercimekle doldurulduğunu göstermekte. Bu da Hitit ekonomisinde ne denli büyük öneme sahip olduğunun ve şehrin zenginliğini gösteriyor. Bu yapı, Şapinuva'da bulduğumuz en büyük silo yapısı."
Kaynak:![]()

Türkçe karakter kullanılmayan ve büyük harflerle yazılmış yorumlar onaylanmamaktadır.